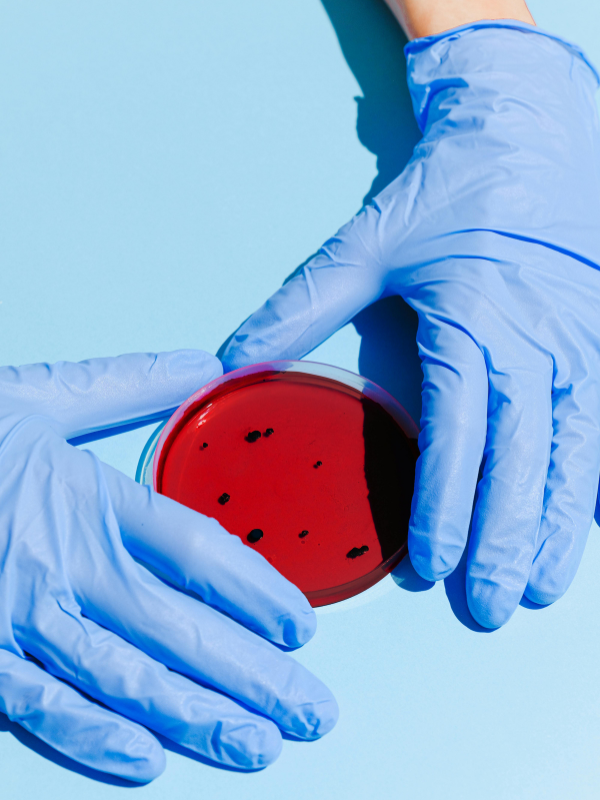

Resources
Advanced eText Collection Medicine (THA)
Description
Wiley's Advanced eText Collection: Medicine ประกอบด้วยหนังสือกว่า 80 รายการที่ครอบคลุมสาขาวิชามากกว่า 40 สาขา ให้การเข้าถึงหนังสือที่หลากหลายสำหรับนักศึกษา นักวิจัย และคณาจารย์เพื่อศึกษาวิจัยทางการแพทย์ในวงกว้าง เป็นครั้งแรกที่รายการเหล่านี้พร้อมให้บริการผ่าน Wiley Online Library สำหรับการซื้อครั้งเดียว
ช่วยให้สถาบันของคุณสนับสนุนเส้นทางทางการแพทย์อย่างครบวงจรด้วยการขยายการเข้าถึงเนื้อหาที่ไม่เคยนำเสนอออนไลน์มาก่อน:
- จัดหาหนังสือที่สอดคล้องกับความต้องการและโครงการวิจัยของสถาบันคุณ เพื่อให้มั่นใจว่าบุคลากรจะนำไปใช้ในการวางแผนการรักษาและการเรียนรู้
- เสริมศักยภาพนักวิจัยและแพทย์ให้ใช้ประโยชน์จากความรู้เชิงลึกที่นำเสนอในหนังสือระดับสูงเหล่านี้เพื่อก้าวหน้าในการศึกษาวิจัย
- สนับสนุนประสบการณ์การเรียนรู้อย่างต่อเนื่องด้วยการให้การเข้าถึงแบบ DRM free สำหรับเนื้อหาที่จำเป็นสำหรับบุคลากรโรงพยาบาล คณาจารย์ และผู้ปฏิบัติงาน
ติดต่อผู้จัดการบัญชีของคุณวันนี้เพื่อข้อมูลเพิ่มเติมเกี่ยวกับ Advanced eText Collections ใหม่ของเรา หรืออีเมล libraryapac@wiley.com
Collection includes
No items found.



